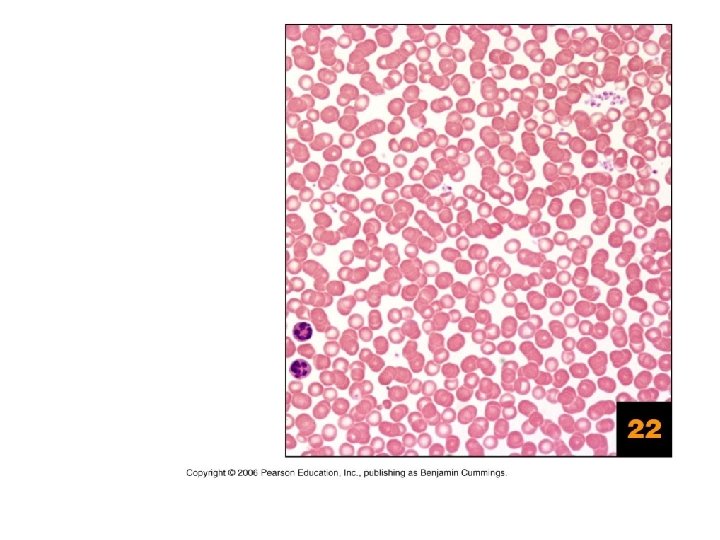

Tissue The Living Fabric PART A Tissues Groups

Tissue: The Living Fabric PART A

Tissues Groups of cells similar in structure and function ¡ The four types of tissues l Epithelial l Connective l Muscle l Nervous ¡ 2

Epithelial Tissue Cellularity – composed almost entirely of cells ¡ Form continuous sheets held together by tight junctions and desmosomes ¡ Polarity – apical and basal surfaces ¡ 3

Epithelial Tissue Attached to a basement membrane l Lamina lucida (basal) l Lamina densa (reticular) ¡ Avascular but innervated – contains no blood vessels but supplied by nerve fibers ¡ Regenerative – rapidly replaces lost cells by cell division ¡ 4

Classification of Epithelia Figure 54. 1 a

Classification of Epithelia 6 Figure 4. 1 b

Epithelia: Simple Squamous Single layer of flattened cells l Disc-shaped nuclei l Sparse cytoplasm ¡ Functions l Diffusion and filtration l Provide a slick, friction-reducing lining in lymphatic and cardiovascular systems ¡ 7

Epithelia: Simple Squamous ¡ Present in the kidney glomeruli, lining of heart, blood vessels, lymphatic vessels, and serosae 8

9

Epithelia: Simple Cuboidal Single layer of cube-like cells l Spherical central nuclei ¡ Function in secretion and absorption ¡ Present in kidney tubules, ducts and secretory portions of small glands, and ovary surface ¡ 10

11

Epithelia: Simple Columnar Single layer of tall cells l Oval nuclei; many contain cilia ¡ Goblet cells are often found in this layer ¡ Function in absorption and secretion ¡ Nonciliated type line digestive tract and gallbladder ¡ 12

Epithelia: Simple Columnar Ciliated type line small bronchi, uterine tubes, and some regions of the uterus ¡ Cilia help move substances through internal passageways ¡ 13

14

Epithelia: Pseudostratified Columnar Single layer of cells with different heights; some do not reach the free surface ¡ Nuclei are seen at different layers ¡ Function in secretion and propulsion of mucus ¡ Present in the male sperm-carrying ducts (nonciliated) and trachea (ciliated) ¡ 15

16

Epithelia: Stratified Squamous Thick membrane composed of several layers of cells ¡ Function in protection of underlying areas subjected to abrasion ¡ Forms the external part of the skin’s epidermis (keratinized cells), and linings of the esophagus, mouth, and vagina (nonkeratinized cells) ¡ 17

18

Epithelia: Stratified Cuboidal and Columnar ¡ Stratified cuboidal l Quite rare in the body l Found in some sweat and mammary glands l Typically two cell layers thick 19

Epithelia: Stratified Cuboidal and Columnar ¡ Stratified columnar l Limited distribution in the body l Found in the male urethra, and lining some glandular ducts l Also occurs at transition areas between two other types of epithelia 20

Epithelia: Transitional Several cell layers, basal cells are cuboidal, surface cells are dome shaped ¡ Stretches to permit the distension of the urinary bladder ¡ Lines the urinary bladder, ureters, and part of the urethra ¡ 21

22

Epithelia: Glandular A gland is one or more cells that produces secretion ¡ Classified by: l Site of secretion release ¡ Endocrine ¡ Exocrine l Number of cells forming the gland l Unicellular ¡ Goblet cell 23 l Multicellular ¡

Glands Classification Site of secretion release Number of cells endocrine Unicellular goblet exocrine multicellular 24

Endocrine Glands ¡ Ductless glands l The product is secreted into the interstitial fluid l Hormones l Secretions include amino acids, proteins, glycoproteins, and steroids 25

Exocrine Glands More numerous than endocrine glands ¡ Secrete their products onto body surfaces (skin) or into body cavities ¡ Examples include mucous, sweat, oil, and salivary glands ¡ Multicellular exocrine glands are composed of a duct and secretory unit ¡ 26

Goblet. Cell 27 Figure 4. 3 b

Classification of exocrine multicellular glands Structure of the Shape of the duct secretory part Simple Tubular Compound Alveolar Tubuloalveolar 28

Structural Classification of Multicellular Exocrine Glands 29 Figure 4. 4 a–d

Structural Classification of Multicellular Exocrine Glands 30 Figure 4. 4 e–g

Classification of exocrine multicellular glands Mode of secretion Type of secretion Merocrine or eccrine pancreas, sweat, and salivary glands Apocrine Mammary Serous Watery with enzymes Parotid Holocrine sebaceous Mucous Viscous with mucin Intestinal glands 31

Mechanisms of Glandular Secretion 32

Connective Tissue ¡ Found throughout the body; most abundant and widely distributed in primary tissues l Embryonic ¡ Mesenchyme l Adult 33

Classification of Adult Connective Tissues 34

Functions of Connective Tissue Binding and support ¡ Protection ¡ Insulation ¡ Transportation ¡ 35

Characteristics of Connective Tissue ¡ Connective tissues have: l Mesenchyme as their common tissue of origin l Varying degrees of vascularity l Nonliving extracellular matrix ¡ ground substance ¡ fibers ¡ cells 36

Structural Elements of Connective Tissue Ground substance – unstructured material that fills the space between cells ¡ Fibers – collagen, elastic, or reticular ¡ Cell population – fibroblasts, chondroblasts, osteoblasts, etc ¡ 37

Ground Substance Composition Interstitial (tissue) fluid ¡ Adhesion proteins – fibronectin and laminin. Attaches cells to matrix components ¡ Proteoglycans – glycosaminoglycans (GAGs) l Functions as a molecular sieve through which nutrients diffuse between blood capillaries and cells ¡ 38

Ground Substance: Proteoglycan Structure 39 4. 7 Figure

Fibers Collagen – tough; provides high tensile strength. White fibers ¡ Elastic – long, thin fibers that allow for stretch. Yellow fibers ¡ Reticular – branched collagenous fibers that form delicate networks ¡ 40

Cells Fibroblasts – connective tissue proper ¡ Chondroblasts – cartilage ¡ Osteoblasts – bone ¡ Hematopoietic stem cells – blood ¡ White blood cells, plasma cells, macrophages, and mast cells ¡ Adipocytes ¡ 41

Connective Tissue: Embryonic ¡ Mesenchyme – embryonic connective tissue l Gel-like ground substance with fibers and star-shaped mesenchymal cells l Gives rise to all other connective tissues l Found in the embryo 42

Connective Tissue Proper: Loose ¡ Areolar connective tissue l Gel-like matrix with all three connective tissue fibers l Fibroblasts, macrophages, mast cells, and some white blood cells l Wraps and cushions organs l Widely distributed throughout the body l Well vascularized 43

Areolar Connective Tissue 44 Figure 4. 8

45

Connective Tissue Proper: Loose ¡ Adipose connective tissue l Closely packed adipocytes l Well vascularized l Found under skin, around kidneys, within abdomen, etc l Local fat deposits serve nutrient needs of highly active organs l White fat vs. brown fat 46

47

Connective Tissue Proper: Loose ¡ Reticular connective tissue l Loose ground substance with reticular fibers l Reticular cells lie in a fiber network l Forms a soft internal skeleton, or stroma, that supports other cell types l Found in lymph nodes, bone marrow, and the spleen 48

49

50

Connective Tissue Proper: Elastic Rich in elastic fibers ¡ Allow expansion and contraction of organs ¡ Present in the ligamentum flavum, walls of blood vessels ¡ 51

52

Connective Tissue Proper: Dense Regular Parallel collagen fibers with a few elastic fibers ¡ Major cell type is fibroblasts ¡ Attaches muscles to bone or to other muscles, and bone to bone ¡ Found in tendons, ligaments, and aponeuroses ¡ Poorly vacularized ¡ 53

54

55

Connective Tissue Proper: Dense Irregularly arranged collagen fibers with some elastic fibers ¡ Major cell type is fibroblasts ¡ Withstands tension in many directions providing structural strength ¡ Found in the dermis, submucosa of the digestive tract, and fibrous organ capsules ¡ Poorly vascularized 56 ¡

57

58

Connective Tissue: Hyaline Cartilage Amorphous, firm matrix with imperceptible network of collagen fibers ¡ Chondrocytes lie in lacunae ¡ Supports, reinforces, cushions, and resists compression ¡ Forms the costal cartilage ¡ Found in embryonic skeleton, the end of long bones, nose, trachea, and larynx ¡ Avascular 59 ¡

60

Connective Tissue: Elastic Cartilage Similar to hyaline cartilage but with more elastic fibers ¡ Maintains shape and structure while allowing flexibility ¡ Supports external ear (pinna) and the epiglottis ¡ 61

62

Connective Tissue: Fibrocartilage Cartilage Matrix similar to hyaline cartilage but less firm with thick collagen fibers ¡ Provides tensile strength and absorbs compression shock ¡ Found in intervertebral discs, the pubic symphysis, and in discs of the knee joint ¡ 63

64

Connective Tissue: Bone (Osseous Tissue) Hard, calcified matrix with collagen fibers found in bone ¡ Osteocytes are found in lacunae and are well vascularized ¡ Supports, protects, and provides levers for muscular action ¡ Stores calcium, minerals, and fat ¡ Marrow inside bones is the site of hematopoiesis ¡ 65

Connective Tissue: Bone (Osseous Tissue) 66 Figure 4. 9 i

67

Connective Tissue: Blood Red and white cells in a fluid matrix (plasma) ¡ Contained within blood vessels ¡ Functions in the transport of respiratory gases, nutrients, and wastes ¡ 68

Blood 69 Figure 4. 9 j

Muscle Tissue: Skeletal Long, cylindrical, multinucleate cells with obvious striations ¡ Initiates and controls voluntary movement ¡ Found in skeletal muscles that attach to bones or skin ¡ 71

72

73

Muscle Tissue: Cardiac Branching, striated, uninucleate cells interlocking at intercalated discs ¡ Propels blood into the circulation ¡ Found in the walls of the heart ¡ 74

75

Muscle Tissue: Smooth Sheets of spindle-shaped cells with central nuclei that have no striations ¡ Propels substances along internal passageways (i. e. , peristalsis) ¡ Found in the walls of hollow organs ¡ 76

77

Nervous Tissue Branched neurons with long cellular processes and support cells ¡ Transmits electrical signals from sensory receptors to effectors ¡ Found in the brain, spinal cord, and peripheral nerves ¡ 78

Nervous Tissue 79 Figure 4. 10

80

Body Membranes ¡ ¡ Epithelial l Mucous l Serous l Cutaneous Synovial 81

Membranes 82 Figure 4. 17 a-d

Epithelial Membranes: Cutaneous Membrane • Cutaneous – skin 83 Figure 4. 12 a

Epithelial Membranes: Mucous Membrane • Mucous – lines body cavities open to the exterior (e. g. , digestive and respiratory tracts) 84 Figure 4. 12 b

Epithelial Membranes: Serous moist membranes found in Membranes closed ventral body cavity 85 Figure 4. 12 c

Tissue Injury and Repair Characterized by 2 phases ¡ First phase l Inflammation ¡ Second phase l Repair ¡ Organization ¡ Regeneration and Fibrosis ¡ 86

Inflammation Injury ¡ Stimulation of mast cells ¡ Release of histamine and heparin l Increased blood flow l Increased blood vessel permeability Inflammation ¡ Swelling Redness Pain Warmth 87

Inflammation ¡ ¡ Necrosis Pus x abscess Blood clot formation l Scab Damaged cells, tissue components and dangerous microorganisms removed l Infection avoided 88

Inflammation 89 Figure 4. 21

Organization ¡ Granulation tissue formation l New blood vessels, l Proliferation of fibroblasts l Growth factors released l Macrophages clean the area ¡ Replaces the blood clot 90

Tissue Repair • Organization and restored blood supply – The blood clot is replaced with granulation tissue • Regeneration and fibrosis – Surface epithelium regenerates and the scab detaches 91 Figure 4. 13 a

Regeneration ¡ Regeneration l New epithelial tissue is formed l Fibrous tissue or scar matures 92

Tissue Repair • Fibrous tissue matures and begins to resemble the adjacent tissue 93 Figure 4. 13 b

Tissue Repair • Results in a fully regenerated epithelium with underlying scar tissue 94 Figure 4. 13 c

Tissue Capacity of regeneration a) b) c) d) Highly: epithelial, bone, areolar, dense irregular, hematopoietic tissue Moderate: smooth muscle, dense regular Weak: skeletal muscle, cartilage No regeneration: cardiac, nervous tissues 95
- Slides: 95